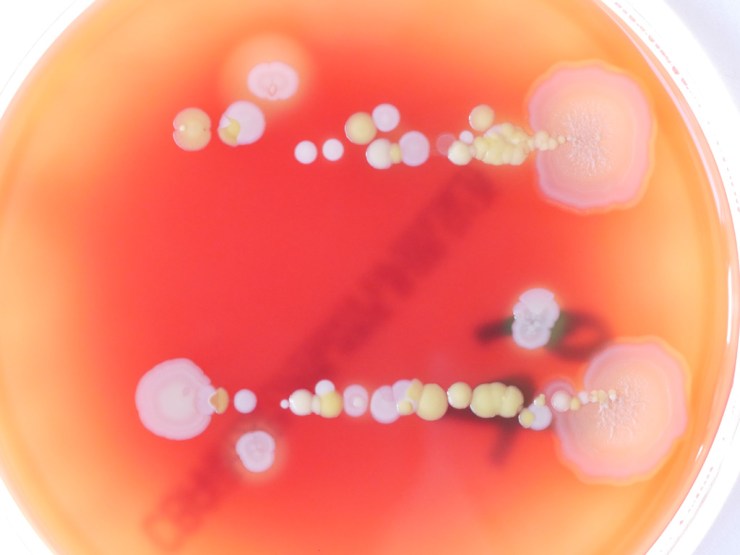

For our new exhibition, Bacterial World, we embarked an exciting science/art experiment to make visible the colonies of bacteria present on a wide range of our everyday items and belongings. Once cultured and photographed, eight of these colonies were captured by artist Elin Thomas as a set of crochet artworks that are on display in the exhibition. Our exhibitions officer Kelly Richards tells us more…
For every human cell in your body, a bacterial cell is also present. These bacteria are part of our microbiome, a vast array of microorganisms that use our body as a home and our food as a source of nutrients. In return, the bacteria help us to digest food, maintain our immune systems and keep dangerous bacteria at bay. In fact without these bacteria we would be very sick indeed.
It’s hard to see our microbiome because individual bacteria can easily be as small as 0.2 microns; you could fit over a thousand of these smallest bacteria on one side of a red blood cell. But if we can select and artificially grow the bacteria, their colonies become living, breathing cities visible to the naked eye.



Click the images above to find out more about culturing bacterial colonies
Colonies, both natural and artificial, can contain billions of bacteria as well as the materials that they secrete such as slime, which helps them to move across surfaces, and antibiotics, which kill off other bacterial colonies that could compete for food and space. In their attempts to dominate the space and food available, as well as get enough oxygen to live, colonies can create beautiful, complex structures.
We had a go at visualising the bacteria that live invisibly alongside us by asking visitors to take part in a simple experiment. With the help of microbiologist Rachael Wilkinson, we took items such as coins, keys and jewellery and touched them lightly against agar plates – dishes containing a nutrient-rich jelly that aids bacterial growth. The agar plates were then given to Nicole Stoesser, a clinical microbiologist at the John Radcliffe Hospital, who grew them in the safe environment of the laboratory.








Many different types of colonies grew from the objects we printed. In the collage above, eight of these colonies have been represented as crocheted Petri dishes by artist Elin Thomas. These artworks are on display in the Bacterial World exhibition until 28 May 2019.
In the gallery below is a photograph of every participant’s plate, whether anything grew in it or not. Click on an image to see a larger version. If you took part in the experiment you will be able to identify your own plate from its number.
The results go to show that we really are living in a bacterial world!

[…] contemporary scientific research with contemporary art. In recent years this has included Elin Thomas’s crocheted petri dishes, Ian Kirkpatrick’s migration and genetics-themed installation, and who could forget the enormous […]